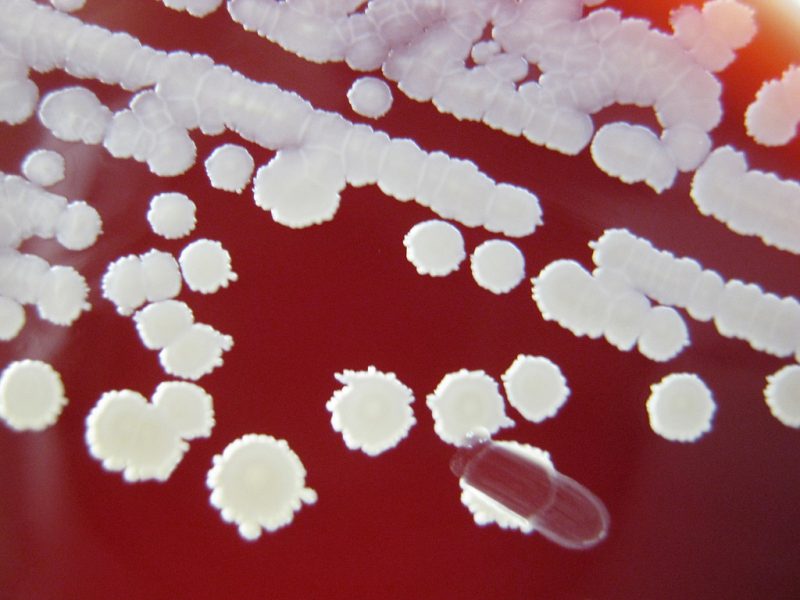
Galinnarum

Стафилококковая инфекция в настоящее время получила широкое распространение.
Сталкиваясь с осложнениями, которые может вызывать стафилококк, возникают вопросы:
Стафилококк: что это такое?

Стафилококковая инфекция – это размножение, проникших в организм человека, шарообразных бактерий – грамположительных кокков, провоцирующих развитие заболеваний воспалительного характера. Микроорганизмы группы Staphylococcus присутствуют в грунте, воздухе, а также являются частью кожной микрофлоры человека и животных.
При благоприятных условиях в процессе наращивания своих колоний стафилококки поражают:
Врачи отмечают, что стафилококки представляют собой группу бактерий, из которых наиболее известны Staphylococcus aureus и Staphylococcus epidermidis. Эти микроорганизмы могут вызывать различные инфекции, от легких кожных заболеваний до серьезных системных инфекций. Диагностика стафилококковых инфекций обычно включает микробиологическое исследование образцов, таких как кровь, моча или мазки с пораженных участков. Важно учитывать, что некоторые штаммы, особенно метициллин-резистентный Staphylococcus aureus (MRSA), требуют особого подхода к лечению. Врачи подчеркивают, что выбор антибиотиков должен основываться на результатах чувствительности, а в случае тяжелых инфекций может потребоваться комбинированная терапия. Профилактика, включая соблюдение гигиенических норм и своевременное лечение ран, играет ключевую роль в снижении риска стафилококковых инфекций у взрослых.
https://youtube.com/watch?v=YgauKl29i6Q
Как передается бактериальная инфекция?

Стафилококк – это коварная бактерия, которая, присутствуя в организме человека, может себя не проявлять до определенного момента сбоя защитной иммунной функции в силу влияния различных вирусов и микроорганизмов, приводящих к поражению слизистых и кожи. Зачастую люди с устойчивым иммунитетом являются носителями стафилококковой инфекции и источником ее распространения.
Так, заражение может происходить:

Группа риска
В группу риска инфицирования стафилококком включены:
Стафилококковая болезнь поражает зачастую новорожденных младенцев и людей пожилого возраста.
Стафилококк — это группа бактерий, которая может вызывать различные инфекции у человека. Существует несколько видов стафилококков, наиболее известный из которых — Staphylococcus aureus. Он может стать причиной кожных заболеваний, пневмонии, а также более серьезных инфекций, таких как сепсис. Диагностика стафилококковых инфекций обычно включает анализы крови, мазки из пораженных участков и посевы на питательные среды. Лечение зависит от типа инфекции и может включать антибиотики, однако устойчивость некоторых штаммов к лекарствам вызывает опасения. Важно помнить, что самолечение может привести к осложнениям, поэтому при подозрении на инфекцию следует обращаться к врачу. Профилактика включает соблюдение гигиенических норм и своевременное лечение любых повреждений кожи.
https://youtube.com/watch?v=ARu6i7bxOWY
Разновидности стафилококка
В медицинской практике специалисты акцентируют внимание на часто проявляемых разновидностях стафилококков. Таковыми являются следующие виды:
Золотистый

Его еще называют желтый стафилококк. Этот вид кокков способен вызывать воспаления всех органов человеческого организма, является самой опасной и трудноизлечимой инфекцией, которая устойчива к высоким температурам, антибиотикам широко спектра действия, ультрафиолетовому излучению, обработке спиртом и перекисью водорода, проявляет себя образованием гнойников и язв на кожном покрове и слизистых.
Зеленый

Зеленящий стафилококк – когда речь идет об этом виде кокков, то в большинстве случаев подразумевается не стафилококк, а зеленящий стрептококк, который представляет собой также шаровидную бактерию, провоцирующую такие же заболевания, что и стафилококк, отличие заключается лишь в строении микроорганизмов, стрептококк зеленящий обитает в полости рта, характеризуется поражением слизистой ЛОР-органов и зубов.
Эпидермальный
Этот белый стафилококк обитает на слизистых, при стойком иммунитете не опасен для человека, при его отсутствии провоцирует внутреннее воспаление сердца.
Сапрофитный
Также относится к группе белых стафилококков. Этот микроорганизм, размножающийся на слизистых оболочках половых органов, чаще всего диагностируется у женщин, вызывая воспаление мочеиспускательных путей.
Simulans
Стафилококк симуланс – вызывает осложнения воспалительного характера всех органов человеческого организма.
Galinnarum
Стафилококк галлинарум – провоцирует пищевые отравления, расстройства функционирования пищеварительной системы, протекающие на фоне воспалительных процессов.
Ворнери
Staphylococcus warneri —, при высоком показателе в бакпосеве этот микроорганизм требует лечения, при минимальных количествах не представляет опасности для человека.
Чем опасен для человека стафилококк?

Стафилококковая инфекция наносит здоровью людей колоссальный вред.
Этот вид инфекции опасен тем, что является одной из первопричин таких сложных заболеваний, как:
|
дерматиты различной сложности |
фурункулез, акне, гнойники, шелушение, зуд, покраснение кожи, ожоговый синдром |
|
недуги опорно-двигательного аппарата |
артрит, остеомиелит |
|
интоксикация организма |
токсический шок |
|
воспаление ЛОР-органов |
стафилококковая ангина |
|
воспаление сердца |
стафилококковый эндокардит |
|
воспаление легких |
пневмония, плеврит |
|
воспаления ЖКТ |
энтероколит, энтерит |
|
воспаление мозга |
менингит, абсцесс |
|
заражение крови |
сепсис |
|
воспаление мочеполовой системы |
уретрит, цистит |
|
поражение глаз |
жжение, зуд, конъюнктивит, отеки век, светобоязнь |
Отсутствие лечения стафилококка может привести к инвалидности человека либо летальному исходу.
Факторы, провоцирующие заболевание

В активную фазу размножения инфекция переходит в моменты:
Основные причины стафилококка, обуславливающие попадание в организм здорового человека бактериальной инфекции:
Симптоматика недуга

Признаки стафилококка схожи с протеканием простудных заболеваний. Такие симптомы, как слезотечение, насморк, слабость, легкая тошнота, повышенная температура тела, схожи с гриппом. Но если заболевший человек не уделяет лечению должного внимания, инфекция обретает более выраженный характер с такой симптоматикой, как:

В начале заражения инфекцией следует обращать внимание на такие признаки, как:
Особенности диагностики стафилококка

При подозрении на развитие бактериальной стафилококковой инфекции и в целях исключения у больного развития скарлатины, сальмонеллеза, туляремии, ротавируса или менингита, лечащий врач направляет больного на сдачу таких анализов, как:
Диагностика и определение вида стафилококка возможна только в лабораторных специализированных условиях медицинских учреждений. Результаты бактериального посева позволяют врачу выявить стадию активности инфекции и определиться с назначением больному действующих противомикробных препаратов в отношении того или иного вида стафилококка.
Стадии протекания инфекционного заболевания
Специалисты различают четыре степени протекания стафилококковой инфекции:
Медикаментозная противостафилококковая терапия

Лечение любого вида стафилококка заключается в назначении антибиотиков. Антибиотикограмма, которая выполняется в лабораторных условиях медучреждения, куда обратился больной, позволяет исследовать реакцию бактерий на тот или иной антибиотик и назначить пациенту необходимый препарат.
Лечить стафилококковую инфекцию у взрослых в домашних условиях не рекомендуется. Лекарственные препараты назначает только лечащий доктор. Если стафилококком заражен один член семьи, остальным назначается профилактическая терапия.
В стационарных условиях медучреждений избавиться от стафилококка помогают антибиотики широко спектра действия пенициллинового ряда, цефалоспорины и трициклические гликопептиды, макролиды, линкозамиды.

|
Название препарата |
Фармакологическая группа |
Форма выпуска |
Показания |
|
«Амоксициллин» |
пенициллины |
таблетки, суспензия, порошок, раствор для в/м введения |
Staphylococcus spp. |
|
«Клоксациллин» |
пенициллины |
порошок для инъекций |
Streptococcus spp., в том числе S. pneumoniae |
|
«Оксациллин» |
пенициллины |
таблетки, капсулы, порошок для инъекций |
стафилококковые инфекции, устойчивые к бензилпенициллину и феноксиметилпениииллину |
|
«Ванкомицин» |
трициклические гликопептиды |
раствор для инъекций, порошок для инъекций |
Staphylococcus aureus, Staphylococcus epidermidis |
|
«Цефалексин» |
цефалоспорины |
таблетки, капсулы, суспензия |
Staphylococcus, в том числе пенициллиназообразующих |
|
«Цефотаксим» |
цефалоспорины |
порошок для инъекций |
Staphy-lococcus aureus, в том числе производящих пенициллиназу, Staphylococcus epidermidis |
|
«Цефалотин» |
цефалоспорины |
порошок для инъекций |
Staphylococcus spp., продуцирующие и непродуцирующие пенициллиназу |
|
«Кларитромицин» |
макролиды |
таблетки |
Staphylococcus spp. |
|
«Клиндамицин» |
линкозамиды |
капсулы, гранулы, порошок для суспензии |
Staphylococcus aureus, Staphylococcus epidermidis, продуцирующие и непродуцирующие пенициллиназу |
|
«Мупирацин» |
антибиотик, бактерицидное средство |
мазь |
Staphylococcus aureus (в том числе и устойчивые к метициллину), Staphylococcus epidermidis, Staphylococcus saprophyticus |
|
«Банеоцин» |
полипептиды |
мазь, порошок |
Staphylococcus spp. |

Кожная стафилококковая инфекция поддается лечению обычной зеленкой! Обработка поражений бриллиантовым раствором способствует быстрейшему восстановлению эпидермиса.

Глазной стафилококк лечат при помощи «Тетрациклиновой мази», «Левомицетиновых капель», фторхинолонов в виде капель и мазей.
Профилактические мероприятия
Насколько бы ни была опасна стафилококковая палочка, предотвратить и снизить риски заражения нею организма можно, выполняя профилактические мероприятия.
К таковым относят:
Много шансов для размножения у стафилококков появляется при стрессах, переохлаждениях, перегреве организма, при контакте с аллергенами. Профилактика стафилококковой инфекции заключается в исключении этих факторов, негативно сказывающихся на человеческом иммунитете.
https://youtube.com/watch?v=jYqrv99Y1ys
Вопрос-ответ
Чем лучше всего лечить стафилококк?
Для лечения стафилококковой инфекции применяют антибиотики нового поколения — полусинтетические пенициллины, аминогликозиды и некоторые другие. Также используют бактериофаги — специфические вирусы, которые прицельно уничтожают именно стафилококки.
Основной метод диагностики стафилококковой инфекции?
Основным методом диагностики стафилококковой инфекции является бактериологический анализ. Биоматериал высевается на специальные питательные среды, а затем оценивается характер выросших колоний.
Советы
СОВЕТ №1
Обратите внимание на симптомы. Стафилококковые инфекции могут проявляться различными симптомами, такими как покраснение, отек, гнойные выделения или лихорадка. При появлении этих признаков не откладывайте визит к врачу для диагностики.
СОВЕТ №2
Соблюдайте правила личной гигиены. Регулярное мытье рук с мылом и использование антисептиков помогут снизить риск заражения стафилококком, особенно в общественных местах или при контакте с больными.
СОВЕТ №3
Не занимайтесь самолечением. При подозрении на стафилококковую инфекцию важно обратиться к врачу для назначения правильного лечения. Самостоятельный прием антибиотиков может привести к ухудшению состояния и развитию устойчивости бактерий.
СОВЕТ №4
Следите за состоянием иммунной системы. Здоровый образ жизни, включая правильное питание, физическую активность и достаточный сон, поможет укрепить иммунитет и снизить риск инфекций, в том числе стафилококковых.

